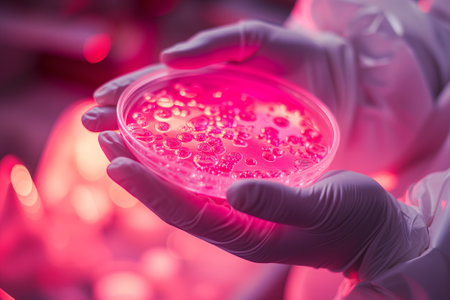
Pink colored bacteria and microbes in a Petri dish in the hands of a man wearing white medical gloves, scientific research on virusesの素材

素材 - Pink colored bacteria and microbes in a Petri dish in the hands of a man wearing white medical gloves, scientific research on viruses
作品情報
Pink colored bacteria and microbes in a Petri dish in the hands of a man wearing white medical gloves, scientific research on viruses
- ID:228340951
- 作品種別:
- 作者名:tatsiana502
キーワード
- agar
- aureus
- background
- bacteria
- bacterial
- bacterium
- biology
- biotechnology
- black
- blood
- cabondioxcine
- cell
- colony
- color
- culture
- danger
- diagnostic
- dish
- gloves
- growth
- hands
- health
- healthcare
- hygiene
- infection
- lab
- laboratory
- man
- media
- medical
- medicine
- medium
- micro
- microbe
- microbes
- microbiology
- nature
- pathogen
- petri
- petri dish
- plate
- red
- research
- risk
- science
- scientific
- sunlight
- test
- viruses
- yellow
類似作品
Close-up of the...
Petri dish clos...
Close up the me...
Salmonella spp....
Probiotics unde...
Dangerous coron...
Gut Bacteria, I...
Abstract hand d...
Gloved hands of...
Petri dish clos...
Petri dish clos...
Bacterial colon...
Bacterial colon...
Portrait of you...
Scientist in pr...
A vibrant portr...
Petri dish clos...
Young african m...
bacterial colon...
Unconventional ...
Bacterial colon...
Helicobacter py...
Petri dish clos...
sour and moldy ...
Doctors hands h...
Macro photograp...
Hand holding of...
Abstract backgr...
Bacterial colon...
Microscopic vie...
Stylish pink pa...
Pink suit men m...
Bacteria
Abstract labora...
A man with a re...
Bacterial colon...
Petri dish with...
Young man with ...
Scientist holdi...
Stylish pink pa...
Scientist analy...
Abstract illust...
A womans face i...
A man's profile...
Threatening hea...
Gloved hand hol...
Gloved hands ho...
Dangerous coron...
Free flowing pi...